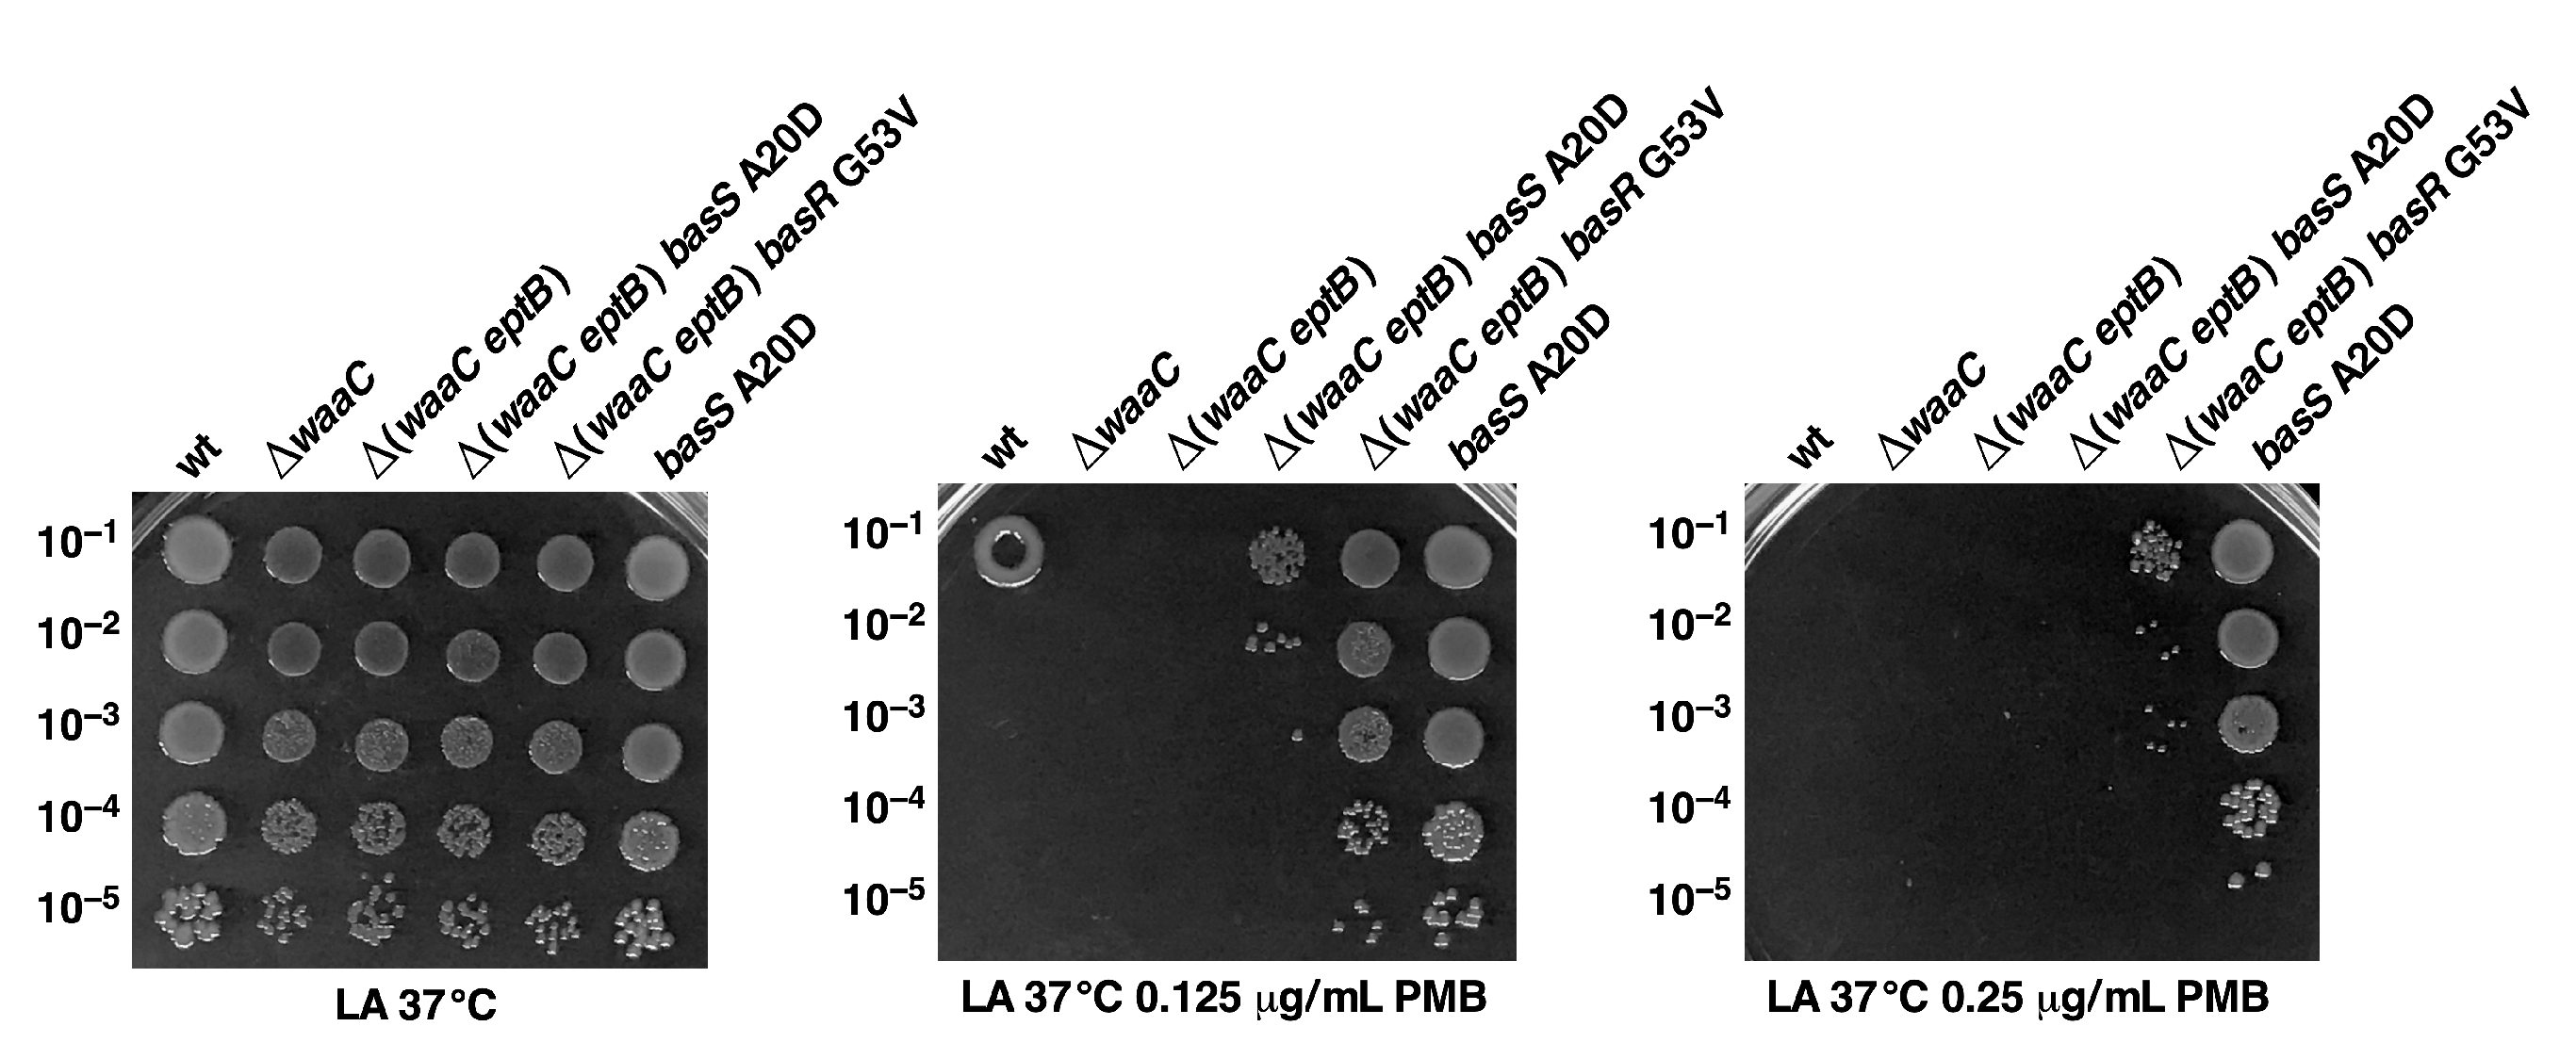
Ijms 22 05099 g011 Ijms 22 05099 g011

Molecular Basis of Essentiality of Early Critical Steps in the Lipopolysaccharide Biogenesis in Escherichia coli K-12: Requirement of MsbA, Cardiolipin, LpxL, LpxM and GcvB
Abstract
1. Introduction
2. Results
2.1. Strains Lacking the Entire waa Locus Synthesize LPS Composed of Glycosylation-Free Lipid IVA and Can Incorporate Lauryl, Myristoyl, and Palmitoleate Chains under Slow-Growth Conditions
2.2. Construction and Properties of Strains Lacking Three Late Acyltransferases in Δ(gmhD–waaA) Derivatives
2.3. Isolation of Extragenic Suppressors That Allow the Growth of Either waaA or (gmhD–waaA) Deletion Derivatives at 37 °C
2.4. Incorporation of P-EtN and Palmitate Chains in Δ(gmhD–waaA) with a Single-Amino-Acid Suppressor Mutation in the msbA Gene
2.5. FtsH Protease Becomes Non-Essential in the ΔwaaA Background at 21 °C
2.6. The Cardiolipin Synthase ClsA Is Essential for the Viability of Strains Lacking Either Three Late Acyltransferases, LpxL, or the Kdo Transferase WaaA and the Conditional Lethality of Δ(lpxM clsA) Bacteria, Which Can Be Suppressed by Mutations in the LPS Transporter MsbA
2.7. The Absence of EptB in the ΔwaaC Background Confers Ca++ Sensitivity, Which Can Be Rescued by the Mutations in Either the basS or the basR Gene That Confer Polymyxin B Resistance
2.8. Constitutive Induction of BasS/R Regulon due to basS A20D and basR G53V Mutations That Suppress the Ca++ Sensitivity of Δ(waaC eptB) Strains
2.9. A Single-Amino-Acid Suppressor basS A20D Mutation Induces Modification of Lipid A by P-EtN and L-Ara4N
2.10. Overexpression of the eptA Gene Can Alleviate the Ca++ Sensitivity of Δ(waaC eptB) Bacteria
2.11. Constitutive basS/R Suppressor Mutations Confer Polymyxin B Resistance
2.12. The Absence of WaaF, but Not That of WaaG or WaaP, also Confers Sensitivity to Ca++ When EptB Is Simultaneously Absent
2.13. Relief of Translational Repression of EptB in the Absence of MgrR sRNA Abrogates the P-EtN Incorporation in the Lipid A
2.14. A Single-Amino-Acid Suppressor Mutation in OppA Alleviates Permeability Defects of ΔwaaC and Allows a Deletion of the surA Gene in the Absence of WaaC Heptosyltransferase
2.15. Overexpression of GcvB sRNA Represses LpxC Amounts in the Wild Type and Suppresses ΔlapAB Lethality
3. Discussion
4. Materials and Methods
4.1. Bacterial Strains, Plasmids and Media
4.2. The Isolation of Extragenic Suppressors of Δ(gmhD-waaA) Mutants and Their Mapping
4.3. The Isolation of Ca++-Resistant Extragenic Suppressors of Δ(waaC eptB) Mutants and Their Mapping
4.4. Quantification of BasS/R Activation by the Measurement of eptA–lacZ and arnB–lacZ Activity
4.5. Cloning, Expression and Disruption of GcvB sRNA
4.6. Western Blot Analysis and Immunodetection of OppA::3XFLAG and LpxC
4.7. LPS Extraction and Its Analysis
4.8. Mass Spectrometry
Author Contributions
Funding
Institutional Review Board Statement
Informed Consent Statement
Data Availability Statement
Acknowledgments
Conflicts of Interest
References
- Nikaido, H. Molecular basis of bacterial outer membrane permeability revisited. Microbiol. Mol. Biol. Rev. 2003, 67, 593–656. [Google Scholar] [CrossRef]
- Raetz, C.R.H.; Whitfield, C. Lipopolysaccharide endotoxin. Ann. Rev. Biochem. 2002, 71, 635–700. [Google Scholar] [CrossRef] [PubMed]
- Klein, G.; Raina, S. Regulated assembly of LPS, its structural alterations and cellular response to LPS defects. Int. J. Mol. Sci. 2019, 20, 356. [Google Scholar] [CrossRef] [PubMed]
- Bohl, T.E.; Aihara, H. Current progress in the structural and biochemical characterization of proteins involved in the assembly of lipopolysaccharide. Int. J. Microbiol. 2018, 2018, 5319146. [Google Scholar] [CrossRef] [PubMed]
- Gronow, S.; Brade, H. Lipopolysaccharide biosynthesis: Which steps do bacteria need to survive? J. Endotoxin Res. 2001, 7, 3–23. [Google Scholar] [CrossRef] [PubMed]
- Anderson, M.S.; Bulawa, C.E.; Raetz, C.R.H. The biosynthesis of Gram-negative endotoxin. Formation of lipid A precursors from UDP-GlcNAc in extracts of Escherichia coli. J. Biol. Chem. 1985, 260, 15536–15541. [Google Scholar] [CrossRef]
- Galloway, S.M.; Raetz, C.R. A mutant of Escherichia coli defective in the first step of endotoxin biosynthesis. J. Biol. Chem. 1990, 265, 6394–6402. [Google Scholar] [CrossRef]
- Anderson, M.S.; Bull, H.G.; Galloway, S.M.; Kelly, T.M.; Mohan, S.; Radika, K.; Raetz, C.R. UDP-N-acetylglucosamine acyltransferase of Escherichia coli. The first step of endotoxin biosynthesis is thermodynamically unfavourable. J. Biol. Chem. 1993, 268, 19858–19865. [Google Scholar] [CrossRef]
- Klein, G.; Kobylak, N.; Lindner, B.; Stupak, A.; Raina, S. Assembly of lipopolysaccharide in Escherichia coli requires the essential LapB heat shock protein. J. Biol. Chem. 2014, 289, 14829–14853. [Google Scholar] [CrossRef] [PubMed]
- Ogura, T.; Inoue, K.; Tatsuta, T.; Suzaki, T.; Karata, K.; Young, K.; Su, L.H.; Fierke, C.A.; Jackman, J.E.; Raetz, C.R.; et al. Balanced biosynthesis of major membrane components through regulated degradation of the committed enzyme of lipid A biosynthesis by the AAA protease FtsH (HflB) in Escherichia coli. Mol. Microbiol. 1999, 31, 833–844. [Google Scholar] [CrossRef]
- Führer, F.; Langklotz, S.; Narberhaus, F. The C-terminal end of LpxC is required for degradation by the FtsH protease. Mol. Microbiol. 2006, 59, 1025–1036. [Google Scholar] [CrossRef]
- Biernacka, D.; Gorzelak, P.; Klein, G.; Raina, S. Regulation of the first committed step in lipopolysaccharide biosynthesis catalyzed by LpxC requires the essential protein LapC (YejM) and HslVU protease. Int. J. Mol. Sci. 2020, 21, 9088. [Google Scholar] [CrossRef] [PubMed]
- Clairfeuille, T.; Buchholz, K.R.; Li, Q.; Verschueren, E.; Liu, P.; Sangaraju, D.; Park, S.; Noland, C.L.; Storek, K.M.; Nickerson, N.N.; et al. Structure of the essential inner membrane lipopolysaccharide-PbgA complex. Nature 2020, 584, 479–483. [Google Scholar] [CrossRef]
- Babinski, K.J.; Kanjilal, S.J.; Raetz, C.R.H. Accumulation of the lipid A precursor UDP-2,3-diacylglucosamine in an Escherichia coli mutant lacking the lpxH gene. J. Biol. Chem. 2002, 277, 25947–25956. [Google Scholar] [CrossRef]
- Garrett, T.A.; Que, N.L.; Raetz, C.R. Accumulation of a lipid A precursor lacking the 4′-phosphate following inactivation of the Escherichia coli lpxK gene. J. Biol. Chem. 1998, 273, 12457–12465. [Google Scholar] [CrossRef] [PubMed]
- Zhou, P.; Zhao, J. Structure, inhibition, and regulation of essential lipid A enzymes. Biochim. Biophys. Acta Mol. Cell Biol. Lipids 2017, 1862, 1424–1438. [Google Scholar] [CrossRef]
- Belunis, C.J.; Raetz, C.R.H. Biosynthesis of endotoxins. Purification and catalytic properties of 3-deoxy-D-manno-octulosonic acid transferase from Escherichia coli. J. Biol. Chem. 1992, 267, 9988–9997. [Google Scholar] [CrossRef]
- Vorachek-Warren, M.K.; Ramirez, S.; Cotter, R.J.; Raetz, C.R.H. A triple mutant of Escherichia coli lacking secondary acyl chains on lipid A. J. Biol. Chem. 2002, 277, 14194–14205. [Google Scholar] [CrossRef] [PubMed]
- Klein, G.; Lindner, B.; Brabetz, W.; Brade, H.; Raina, S. Escherichia coli K-12 suppressor-free mutants lacking early glycosyltransferase and late acetyltransferases. Minimal lipopolysaccharide structure and induction of envelope stress response. J. Biol. Chem. 2009, 284, 15369–15389. [Google Scholar] [CrossRef]
- Clementz, T.; Bednarski, J.J.; Raetz, C.R.H. Function of the htrB high temperature requirement gene of Escherichia coli in the acylation of lipid A. HtrB catalyzed incorporation of laurate. J. Biol. Chem. 1996, 271, 12095–12102. [Google Scholar] [CrossRef]
- Carty, S.M.; Sreekumar, K.R.; Raetz, C.R.H. Effect of cold shock on lipid A biosynthesis in Escherichia coli. Induction at 12 °C of an acyltransferase specific for palmitoleoyl-acyl carrier protein. J. Biol. Chem. 1999, 274, 9677–9685. [Google Scholar] [CrossRef] [PubMed]
- Clementz, T.; Zhou, Z.; Raetz, C.R.H. Function of the Escherichia coli msbB gene, a multicopy suppressor of htrB knockouts, in the acylation of lipid A. Acylation by MsbB follows laurate incorporation by HtrB. J. Biol. Chem. 1997, 272, 10353–10360. [Google Scholar] [CrossRef] [PubMed]
- Karow, M.; Raina, S.; Georgopoulos, C.; Fayet, O. Complex phenotypes of null mutations in the htr genes, whose products are essential for Escherichia coli growth at elevated temperatures. Res. Microbiol. 1991, 142, 289–294. [Google Scholar] [CrossRef]
- Doerrler, W.T.; Reedy, M.C.; Raetz, C.R.H. An Escherichia coli mutant defective in lipid export. J. Biol. Chem. 2001, 276, 11461–11464. [Google Scholar] [CrossRef] [PubMed]
- Reynolds, C.M.; Raetz, C.R.H. Replacement of lipopolysaccharide with free lipid A molecules in Escherichia coli mutants lacking all core sugars. Biochemistry 2009, 48, 9627–9640. [Google Scholar] [CrossRef] [PubMed]
- Mamat, U.; Wilke, K.; Bramhill, D.; Schromm, A.B.; Lindner, B.; Kohl, T.A.; Corchero, J.L.; Villaverde, A.; Schaffer, L.; Head, S.R.; et al. Detoxifying Escherichia coli for endotoxin-free production of recombinant proteins. Microb. Cell Fact. 2015, 14, 57. [Google Scholar] [CrossRef] [PubMed]
- Zeng, D.; Zhao, J.; Chung, H.S.; Guan, Z.; Raetz, C.R.H.; Zhou, P. Mutants resistant to LpxC inhibitors by rebalancing cellular homeostasis. J. Biol. Chem. 2013, 288, 5475–5486. [Google Scholar] [CrossRef]
- Raetz, C.R.; Reynolds, C.M.; Trent, M.S.; Bishop, R.E. Lipid A modification systems in Gram-negative bacteria. Ann. Rev. Biochem. 2007, 76, 295–329. [Google Scholar] [CrossRef]
- Klein, G.; Stupak, A.; Biernacka, D.; Wojtkiewicz, P.; Lindner, B.; Raina, S. Multiple transcriptional factors regulate transcription of the rpoE gene in Escherichia coli under different growth conditions and when the lipopolysaccharide biosynthesis is defective. J. Biol. Chem. 2016, 291, 22999–23019. [Google Scholar] [CrossRef]
- Reynolds, C.M.; Kalb, S.R.; Cotter, R.J.; Raetz, C.R.H. A phosphoethanolamine transferase specific for the outer 3-deoxy-D-manno-octulosonic acid residue of Escherichia coli lipopolysaccharide. Identification of the eptB gene and Ca2+ hypersensitivity of an eptB deletion mutant. J. Biol. Chem. 2005, 280, 21202–21211. [Google Scholar] [CrossRef] [PubMed]
- Moon, K.; Six, D.A.; Lee, H.J.; Raetz, C.R.H.; Gottesman, S. Complex transcriptional and post-transcriptional regulation of an enzyme for lipopolysaccharide modification. Mol. Microbiol. 2013, 89, 52–64. [Google Scholar] [CrossRef] [PubMed]
- Moon, K.; Gottesman, S. A PhoQ/P-regulated small RNA regulates sensitivity of Escherichia coli to antimicrobial peptides. Mol. Microbiol. 2009, 74, 1314–1330. [Google Scholar] [CrossRef] [PubMed]
- Klein, G.; Lindner, B.; Brade, H.; Raina, S. Molecular basis of lipopolysaccharide heterogeneity in Escherichia coli: Envelope stress-responsive regulators control the incorporation of glycoforms with a third 3-deoxy-α-D-manno-oct-2-ulosonic acid and rhamnose. J. Biol. Chem. 2011, 286, 42787–42807. [Google Scholar] [CrossRef]
- Inoue, T.; Shingaki, R.; Hirose, S.; Waki, K.; Mori, H.; Fukui, K. Genome-wide screening of genes required for swarming motility in Escherichia coli K-12. J. Bacteriol. 2002, 189, 950–957. [Google Scholar] [CrossRef] [PubMed]
- Tan, B.K.; Bogdanov, M.; Zhao, J.; Dowhan, W.; Raetz, C.R.H.; Guan, Z. Discovery of a cardiolipin synthesis utilizing phosphadylethanolamine and phosphadylglycerol as substrates. Proc. Natl. Acad. Sci. USA 2012, 109, 16504–16509. [Google Scholar] [CrossRef]
- Miyakoshi, M.; Chao, Y.; Vogel, J. Cross talk between ABC transporter mRNAs via a target mRNA-derived sponge of the GcvB small RNA. EMBO J. 2015, 34, 1478–1492. [Google Scholar] [CrossRef]
- Lalaouna, D.; Eyraud, A.; Devinck, A.; Prévost, K.; Massé, E. GcvB small RNA uses two distinct seed regions to regulate an extensive targetome. Mol. Microbiol. 2019, 111, 473–486. [Google Scholar] [CrossRef]
- Sharma, C.M.; Papenfort, K.; Pernitzsch, S.R.; Mollenkopf, H.J.; Hinton, J.C.; Vogel, J. Pervasive post-transcriptional control of genes involved in amino acid metabolism by the Hfq-dependent GcvB small RNA. Mol. Microbiol. 2011, 81, 1144–1165. [Google Scholar] [CrossRef]
- Pulvermacher, S.C.; Stauffer, L.T.; Stauffer, G.V. Role of the Escherichia coli Hfq protein in GcvB regulation of oppA and dppA mRNAs. Microbiology 2009, 155, 115–123. [Google Scholar] [CrossRef]
- Coornaert, A.; Chiaruttini, C.; Springer, M.; Guillier, M. Post-transcriptional control of the Escherichia coli PhoQ-PhoP two-component system by multiple sRNAs involves a novel pairing region of GcvB. PLoS Genet. 2013, 9, e1003156. [Google Scholar] [CrossRef]
- Doerrler, W.T.; Raetz, C.R. ATPase activity of the MsbA lipid flippase of Escherichia coli. J. Biol. Chem. 2002, 277, 36697–36705. [Google Scholar] [CrossRef]
- Datsenko, K.A.; Wanner, B.L. One-step inactivation of chromosomal genes in Escherichia coli K-12 using PCR products. Proc. Natl. Acad. Sci. USA 2000, 97, 6640–6645. [Google Scholar] [CrossRef]
- Wojtkiewicz, P.; Biernacka, D.; Gorzelak, P.; Stupak, A.; Klein, G.; Raina, S. Multicopy suppressor analysis of strains lacking cytoplasmic peptidyl-prolyl cis/trans isomerases identifies three new PPIase activities in Escherichia coli that includes the DksA transcription factor. Int. J. Mol. Sci. 2020, 21, 5843. [Google Scholar] [CrossRef]
- Ho, H.; Miu, A.; Alexander, M.K.; Garcia, N.K.; Oh, A.; Zilberleyb, I.; Reichelt, M.; Austin, C.D.; Tam, C.; Shriver, S.; et al. Structural basis for dual-mode inhibition of the ABC transporter MsbA. Nature 2018, 557, 196–201. [Google Scholar] [CrossRef] [PubMed]
- Mi, W.; Li, Y.; Yoon, S.H.; Ernst, R.K.; Walz, T.; Liao, M. Structural basis of MsbA-mediated lipopolysaccharide transport. Nature 2017, 549, 233–237. [Google Scholar] [CrossRef] [PubMed]
- Padayatti, P.S.; Lee, S.C.; Stanfield, R.L.; Wen, P.C.; Tajkhorshid, E.; Wilson, I.A.; Zhang, Q. Structural insights into the lipid A transport pathway in MsbA. Structure 2019, 27, 1114–1123.e3. [Google Scholar] [CrossRef] [PubMed]
- Brabetz, W.; Müller-Loennies, S.; Holst, O.; Brade, H. Deletion of the heptosyltransferase genes rfaC and rfaF in Escherichia coli K-12 results in a Re-type lipopolysaccharide with a high degree of 2-aminoethanol phosphate substitution. Eur. J. Biochem. 1997, 247, 716–724. [Google Scholar] [CrossRef]
- Hagiwara, D.; Yamashino, T.; Mizuno, T. A genome-wide view of the Escherichia coli BasS-BasR two-component system implicated in iron-responses. Biosci. Biotechnol. Biochem. 2004, 68, 1758–1767. [Google Scholar] [CrossRef]
- Froelich, J.M.; Tran, K.; Wall, D. A pmrA constitutive mutant sensitizes Escherichia coli to deoxycholic acid. J. Bacteriol. 2006, 188, 1180–1183. [Google Scholar] [CrossRef] [PubMed][Green Version]
- Raina, S.; Georgopoulos, C. The htrM gene, whose product is essential for Escherichia coli viability only at elevated temperatures, is identical to the rfaD gene. Nucleic Acids Res. 1991, 19, 3811–3819. [Google Scholar] [CrossRef]
- Ittisoponpisan, S.; Islam, S.A.; Khanna, T.; Alhuzimi, E.; Davis, A.; Sternberg, M.J.E. Can predicted protein 3D structures provide reliable insights into whether missense variants are disease associated? J. Mol. Biol. 2019, 431, 2197–2212. [Google Scholar] [CrossRef] [PubMed]
- Richarme, G.; Caldas, T.D. Chaperone properties of the bacterial periplasmic substrate-binding proteins. J. Biol. Chem. 1997, 272, 15607–15612. [Google Scholar] [CrossRef] [PubMed]
- Escobar Garduño, E.; Scior, T.; Soto Urzúla, L.; Martínez Morales, L.J. Identification of residues for chaperone-like activity of OppA protein in Yersinia pseudotuberculosis. AMB Express 2020, 10, 153. [Google Scholar] [CrossRef] [PubMed]
- Guo, M.S.; Updegrove, T.B.; Gogol, E.B.; Shabalina, S.A.; Gross, C.A.; Storz, G. MicL, a new σE-dependent sRNA, combats envelope stress by repressing synthesis of Lpp, the major outer membrane lipoprotein. Genes Dev. 2014, 28, 1620–1634. [Google Scholar] [CrossRef] [PubMed]
- Melamed, S.; Peer, A.; Faigenbaum-Romm, R.; Gatt, Y.E.; Reiss, N.; Bar, A.; Altuvia, Y.; Argaman, L.; Margalit, H. Global mapping of small RNA-target interactions in bacteria. Mol. Cell 2016, 63, 884–897. [Google Scholar] [CrossRef] [PubMed]
- Schnaitman, C.A.; Klena, J.D. Genetics of lipopolysaccharide biosynthesis in enteric bacteria. Microbiol. Rev. 1993, 57, 655–682. [Google Scholar] [CrossRef]
- Rozalski, A.; Brade, L.; Kosma, P.; Appelmelk, B.J.; Krogmann, C.; Brade, H. Epitope specificities of murine monoclonal and rabbit polyclonal antibodies against enterobacterial lipopolysaccharides of the Re chemotype. Infect. Immun. 1989, 57, 2645–2652. [Google Scholar] [CrossRef]
- Bishop, R.E.; Gibbons, H.S.; Guina, T.; Trent, M.S.; Miller, S.I.; Raetz, C.R.H. Transfer of palmitate from phospholipids to lipid A in outer membranes of Gram-negative bacteria. EMBO J. 2000, 19, 5071–5080. [Google Scholar] [CrossRef]
- Hiraoka, S.; Matsuzaki, H.; Shibuya, I. Active increase in cardiolipin synthesis in the stationary growth phase and its physiological significance in Escherichia coli. FEBS Lett. 1993, 336, 221–224. [Google Scholar] [CrossRef]
- Dalebroux, Z.D.; Matamouros, S.; Whittington, D.; Bishop, R.E.; Miller, S.I. PhoPQ regulates acidic glycerophospholipid content of the Salmonella Typhimurium outer membrane. Proc. Natl. Acad. Sci. USA 2014, 111, 1963–1968. [Google Scholar] [CrossRef]
- Corey, R.A.; Pyle, E.; Allen, W.J.; Watkins, D.W.; Casiraghi, M.; Miroux, B.; Arechaga, I.; Politis, A.; Collinson, I. Specific cardiolipin-SecY interactions are required for proton-motive force stimulation of protein. Proc. Natl. Acad. Sci. USA 2018, 115, 7967–7972. [Google Scholar] [CrossRef] [PubMed]
- Koppelman, C.M.; Den Blaauwen, T.; Duursma, M.C.; Heeren, R.M.; Nanning, N. Escherichia coli minicell membranes are enriched in cardiolipin. J. Bacteriol. 2001, 183, 6144–6147. [Google Scholar] [CrossRef] [PubMed]
- Ogasawara, H.; Shinohara, S.; Yamamoto, K.; Ishihama, A. Novel regulation targets of the metal-response BasS-BasR two-component system of Escherichia coli. Microbiology 2012, 158, 1482–1492. [Google Scholar] [CrossRef]
- Missiakas, D.; Betton, J.M.; Raina, S. New components of protein folding in extracytoplasmic compartments of Escherichia coli SurA, FkpA and Skp/OmpH. Mol. Microbiol. 1996, 21, 871–884. [Google Scholar] [CrossRef] [PubMed]
- Rouvière, P.E.; Gross, C.A. SurA, a periplasmic protein with peptidyl-prolyl isomerase activity, participates in the assembly of outer membrane porins. Genes Dev. 1996, 10, 3170–3182. [Google Scholar] [CrossRef]
- Lazar, S.W.; Kolter, R. SurA assists the folding of Escherichia coli outer membrane proteins. J. Bacteriol. 1996, 178, 1770–1773. [Google Scholar] [CrossRef] [PubMed]
- Humes, J.R.; Schiffrin, B.; Calabrese, A.N.; Higgins, A.J.; Westhead, D.R.; Brockwell, D.J.; Radford, S.E. The role of SurA PPIase domains in preventing aggregation of the outer-membrane proteins tOmpA and OmpT. J. Mol. Biol. 2019, 431, 1267–1283. [Google Scholar] [CrossRef]
- Marx, D.C.; Plummer, A.M.; Faustino, A.M.; Devlin, T.; Roskopf, M.A.; Leblanc, M.J.; Lessen, H.J.; Amann, B.T.; Fleming, P.J.; Krueger, S.; et al. SurA is a cryptically grooved chaperone that expands unfolded outer membrane proteins. Proc. Natl. Acad. Sci. USA 2020, 117, 28026–28035. [Google Scholar] [CrossRef]
- Yang, C.; Peng, S.; Chen, C.; Zhao, X.S. Molecular mechanism of networking among DegP, Skp and SurA in periplasm for biogenesis of outer membrane proteins. Biochem. J. 2020, 477, 2949–2965. [Google Scholar] [CrossRef]
- Pagnout, C.; Sohm, B.; Razafitianamaharavo, A.; Caillet, C.; Offroy, M.; Leduc, M.; Gendre, H.; Jomini, S.; Beaussart, A.; Bauda, P.; et al. Pleiotropic effects of rfa-gene mutations on Escherichia coli envelope properties. Sci. Rep. 2019, 9, 9696. [Google Scholar] [CrossRef]
- Prince, C.; Jia, Z. An unexpected duo: Rubredoxin binds nine TPR motifs to form LapB, an essential regulator of lipopolysaccharide synthesis. Structure 2015, 23, 1500–1506. [Google Scholar] [CrossRef]
- Douglass, M.V.; Cléon, F.; Trent, M.S. Cardiolipin aids in lipopolysaccharide transport to the gram-negative outer membrane. Proc. Natl. Acad. Sci. USA 2021, 118, e2018329118. [Google Scholar] [CrossRef]
- Uzzau, S.; Figueroa-Bossi, N.; Rubino, S.; Bossi, L. Epitope tagging of chromosomal genes in Salmonella. Proc. Natl. Acad. Sci. USA 2001, 98, 15264–15269. [Google Scholar] [CrossRef]
- Dartigalongue, C.; Loferer, H.; Raina, S. EcfE, a new essential inner membrane protease: Its role in the regulation of heat shock response in Escherichia coli. EMBO J. 2001, 20, 5908–5918. [Google Scholar] [CrossRef]
- Raina, S.; Missiakas, D.; Baird, L.; Kumar, S.; Georgopoulos, C. Identification and transcriptional analysis of the Escherichia coli htrE operon which is homologous to pap and related pilin operons. J. Bacteriol. 1993, 175, 5009–5021. [Google Scholar] [CrossRef] [PubMed]
- Betton, J.M.; Boscus, D.; Missiakas, D.; Raina, S.; Hofnung, M. Probing the structural role of an αβ loop of maltose-binding protein by mutagenesis: Heat-shock induction by loop variants of the maltose-binding protein that form periplasmic inclusion bodies. J. Mol. Biol. 1996, 262, 140–150. [Google Scholar] [CrossRef] [PubMed]
- Galanos, C.; Lüderitz, O.; Westphal, O. A new method for the extraction of R lipopolysaccharides. Eur. J. Biochem. 1969, 9, 245–249. [Google Scholar] [CrossRef]
- Kanipes, M.I.; Lin, S.; Cotter, R.J.; Raetz, C.R.H. Ca2+-induced phosphoethanolamine transfer to the outer 3-deoxy-D-manno-octulosonic acid moiety of Escherichia coli lipopolysaccharide. A novel membrane enzyme dependent upon phosphatidylethanolamine. J. Biol. Chem. 2001, 276, 1156–1163. [Google Scholar] [CrossRef]
- Kuhn, H.M.; Brade, L.; Appelmelk, B.J.; Kusumoto, S.; Rietschel, E.T.; Brade, H. Characterization of the epitope specificity of murine monoclonal antibodies directed against lipid A. Infect. Immun. 1992, 60, 2201–2210. [Google Scholar] [CrossRef] [PubMed]
- Müller-Loennies, S.; Gronow, S.; Brade, L.; MacKenzie, R.; Kosma, P.; Brade, H. A monoclonal antibody against a carbohydrate epitope in lipopolysaccharide differentiates Chlamydophila psittaci from Chlamydophila pecorum, Chlamydophila pneumoniae, and Chlamydia trachomatis. Glycobiology 2006, 16, 184–196. [Google Scholar] [CrossRef][Green Version]
- Kondakova, A.; Lindner, B. Structural characterization of complex bacterial glycolipids by Fourier transform mass spectrometry. Eur. J. Mass. Spectrom. 2005, 11, 535–546. [Google Scholar] [CrossRef] [PubMed]

| Strains | Genotype | Reference |
|---|---|---|
| BW25113 | lacIq rrnBT14 ΔlacZWJ16 hsdR514 ΔaraBADAH33 ΔrhaBADLD78 | [42] |
| W3110 | λ- IN(rrnD-rrnE)1 rph-1 | Our collection |
| GK1111 | W3110 Δlac | [19] |
| SR9900 | W3110 Δ(waaF–waaA) | This study |
| SR9902 | W3110 Δ(gmhD–waaA) | This study |
| SR9919 | SR9902 msbA P50S | This study |
| SR10123 | SR9902 msbA R310S | This study |
| SR7781 | W3110 Δ(lpxL lpxM lpxP) | [13] |
| SR23225 | SR7781 ΔwaaA | This study |
| SR23234 | SR7781 Δ(gmhD–waaA) | This study |
| GK1162 | W3110 eptB<>aph | [19] |
| GK1181 | W3110 eptB<>frt | [33] |
| SR15676 | GK1181 waaC<>aph | This study |
| SR8649 | GK1181 waaC<>cat | This study |
| SR8503 | SR8649 basS A20D | This study |
| SR23091 | SR8503 Δlac | This study |
| SR23111 | SR23091 φ(eptA–lacZ) | This study |
| SR23114 | SR23091 φ(arnB–lacZ) | This study |
| SR23035 | GK1111 basR G53V | This study |
| GK6128 | SR23035 φ(eptA–lacZ) | This study |
| SR23061 | SR23035 eptB<>aph | This study |
| SR23065 | SR23061 waaC<>cat | This study |
| SR19143 | GK1111 φ(arnB–lacZ) | This study |
| SR23075 | SR19143 basR G53V | This study |
| GK2048 | BW25113 waaF<>cat | [29] |
| SR23201 | GK1181 waaF<>cat | This study |
| SR23205 | GK1181 waaG | This study |
| SR23212 | GK1181 waaP | This study |
| GK2576 | W3110 mgrR<>ada | This study |
| SR17187 | BW25113 lapA–lapB<>aph | [9] |
| SR20491 | BW25113 gcvB<>ada | This study |
| SR22995 | SR20491 Δ(lapA lapB) | This study |
| SR22990 | BW25113 p(plac–gcvB+) | This study |
| SR8320 | W3110 Δ(surA waaC) | This study |
| SR23138 | W3110 oppA<>ada | This study |
| SR23163 | W3110 oppA::3XFLAG | This study |
| SR23179 | SR23163 waaC<>cat | This study |
| GK5504 | BW25113 clsA::Tn10 | [43] |
| SR23279 | SR15676 peptA+ | This study |
| Number of Transductants | |||||
|---|---|---|---|---|---|
| Recipient | Donor | ||||
| ΔwaaA | Δ(gmhD–waaA) | ΔftsH sfhC21 | |||
| M9 21 °C | LA 21 °C | M9 21 °C | LA 21 °C | M9 21 °C | |
| wild type | 3912 | 430 sc | 3211 | 390 sc | 0 |
| Δ(lpxL lpxM lpxP) | 3890 | 0 | 3374 | 0 | ND |
| ΔwaaA + vector alone | ND | ND | 750 | ||
| ΔwaaA + pftsH+ | ND | ND | 966 | ||
| Strains | Mutation Position | Amounts of Isolates |
|---|---|---|
| SR23302 SR23318 SR23319 | S120L (TCA→TTA) | 3 |
| SR23305 SR23307 | M160I (ATG→ATA) | 2 |
| SR23315 | S164C (AGT→TGT) | 1 |
| SR23313 | V287A (GTT→GCT) | 1 |
| SR23309 SR23317 | D431Y (GAT→TAT) | 2 |
| SR23316 | D498Y (GAT→TAT) | 1 |
| SR23303 | I177M (ATT→ATG) N529K (AAC→AAA) | 1 |
| Number of Transductants | ||||
|---|---|---|---|---|
| Recipient | Donor | |||
| ΔsurA | ||||
| M9 30 °C | LA 30 °C | M9 37 °C | LA 37 °C | |
| ΔwaaC | 3 | 6 | 4 | 5 |
| ΔwaaC oppA S273G | 1034 | 1190 | 1274 | 960 |
| Number of Transductants | ||||
|---|---|---|---|---|
| Recipient | Donor | |||
| ΔlapAB | lppA::Tn10 | |||
| M9 30 °C | LA 37 °C | M9 30 °C | LA 37 °C | |
| wild type + vector alone | 530 | 5 | 3830 | 3450 |
| wild type + pgcvB+ + IPTG 90 μM | 3102 | 2545 | ND | ND |
| ΔlapAB + vector alone | ND | ND | 2574 | 2956 |
| ΔlapAB + pslrA+ + IPTG 90 μM | 2975 | 3343 | ND | ND |
Publisher’s Note: MDPI stays neutral with regard to jurisdictional claims in published maps and institutional affiliations. |
© 2021 by the authors. Licensee MDPI, Basel, Switzerland. This article is an open access article distributed under the terms and conditions of the Creative Commons Attribution (CC BY) license (https://creativecommons.org/licenses/by/4.0/).
Share and Cite
Gorzelak, P.; Klein, G.; Raina, S. Molecular Basis of Essentiality of Early Critical Steps in the Lipopolysaccharide Biogenesis in Escherichia coli K-12: Requirement of MsbA, Cardiolipin, LpxL, LpxM and GcvB. Int. J. Mol. Sci. 2021, 22, 5099. https://doi.org/10.3390/ijms22105099
Gorzelak P, Klein G, Raina S. Molecular Basis of Essentiality of Early Critical Steps in the Lipopolysaccharide Biogenesis in Escherichia coli K-12: Requirement of MsbA, Cardiolipin, LpxL, LpxM and GcvB. International Journal of Molecular Sciences. 2021; 22(10):5099. https://doi.org/10.3390/ijms22105099
Chicago/Turabian StyleGorzelak, Patrycja, Gracjana Klein, and Satish Raina. 2021. "Molecular Basis of Essentiality of Early Critical Steps in the Lipopolysaccharide Biogenesis in Escherichia coli K-12: Requirement of MsbA, Cardiolipin, LpxL, LpxM and GcvB" International Journal of Molecular Sciences 22, no. 10: 5099. https://doi.org/10.3390/ijms22105099
APA StyleGorzelak, P., Klein, G., & Raina, S. (2021). Molecular Basis of Essentiality of Early Critical Steps in the Lipopolysaccharide Biogenesis in Escherichia coli K-12: Requirement of MsbA, Cardiolipin, LpxL, LpxM and GcvB. International Journal of Molecular Sciences, 22(10), 5099. https://doi.org/10.3390/ijms22105099

